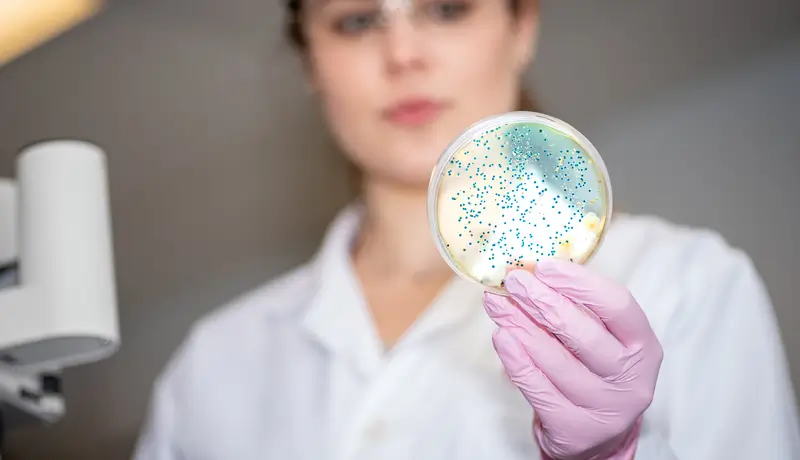
Γυναίκα επιστήμονας σε εργαστήριο κρατώντας πλάκα Petri με βακτήρια σε μικροσκοπική ανάλυση.

ΜΙΚΡΟΒΙΟΛΟΓΙΚΕΣ ΥΠΗΡΕΣΙΕΣ HOMED - ΑΞΙΟΠΙΣΤΑ ΑΠΟΤΕΛΕΣΜΑΤΑ
Διαγνωστικές Λύσεις για Πρόληψη και Υγεία
Πρόληψη, Διάγνωση & Μικροβιολογικό Κέντρο Homed
Στο Μικροβιολογικό Κέντρο της Homed, προσφέρουμε γρήγορες και αξιόπιστες εξετάσεις για να βοηθήσουμε στη διάγνωση και πρόληψη ασθενειών. Το εργαστήριό μας λειτουργεί καθημερινά από τις 07:00 το πρωί, και τα αποτελέσματα είναι διαθέσιμα την ίδια μέρα και αποστέλλονται στο email σας για να σας ενημερώσουμε γρήγορα.
Η Φιλοσοφία του Κέντρου μας
Η φιλοσοφία μας είναι απλή: πρόληψη και γρήγορη διάγνωση. Στόχος μας είναι να βοηθήσουμε τους ασθενείς να ζήσουν υγιέστερα με τις εξής υπηρεσίες:
1. Πρόληψη του Διαβήτη και Ανίχνευση Αντίστασης στην Ινσουλίνη
Η έγκαιρη διάγνωση του διαβήτη και της αντίστασης στην ινσουλίνη είναι θεμελιώδης για την αποφυγή σοβαρών και επικίνδυνων προβλημάτων υγείας. Η έγκαιρη παρέμβαση βοηθά στην αποφυγή ή την καθυστέρηση των επιπλοκών που συνδέονται με την πάθηση. Προσφέρουμε εύκολες και αξιόπιστες εξετάσεις, όπως η γλυκοζυλιωμένη αιμοσφαιρίνη (HbA1c) και η δοκιμή ανοχής γλυκόζης, για να εντοπίσουμε τυχόν ανωμαλίες στη ρύθμιση του σακχάρου και να ξεκινήσουμε τη θεραπεία σε πρώιμο στάδιο.
2. Ρύθμιση του Διαβήτη και Πρόληψη Επιπλοκών
Για τους ασθενείς με διαβήτη, η παρακολούθηση του σακχάρου στο αίμα είναι απαραίτητη για τη σωστή ρύθμιση και την αποφυγή σοβαρών επιπλοκών. Παρέχουμε εξειδικευμένες υπηρεσίες για τη ρύθμιση του σακχάρου και τη διάγνωση προβλημάτων που μπορεί να εμφανιστούν, όπως καρδιοπάθειες, βλάβες στα μάτια και τα νεφρά.

3. Πρόληψη και Αντιμετώπιση Παχυσαρκίας και Μεταβολικού Συνδρόμου
Η παχυσαρκία και το μεταβολικό σύνδρομο είναι κύριοι παράγοντες κινδύνου για ασθένειες, όπως διαβήτης και καρδιοπάθεια. Προσφέρουμε εξετάσεις για να αξιολογήσουμε την υγεία σας και να βοηθήσουμε στην υιοθέτηση ενός πιο υγιεινού τρόπου ζωής, μειώνοντας έτσι τους κινδύνους και βελτιώνοντας τη μεταβολική σας υγεία.
4. Πρόληψη του Καρκίνου
Η έγκαιρη διάγνωση και η πρόληψη του καρκίνου είναι κρίσιμη για τη μείωση των κινδύνων και τη θεραπεία σε πρώιμο στάδιο. Προσφέρουμε εξετάσεις όπως το PSA για τον καρκίνο του προστάτη και το τεστ Παπανικολάου για τον καρκίνο του τραχήλου της μήτρας, με στόχο την έγκαιρη αναγνώριση και παρέμβαση.
5. Υποστήριξη Σεξουαλικής Υγείας
Προσφέρουμε υπηρεσίες για τη σεξουαλική υγεία ανδρών και γυναικών, όπως εξετάσεις ορμονικών προφίλ (π.χ., τεστοστερόνη, οιστρογόνα), που βοηθούν στη διαχείριση διαταραχών της σεξουαλικής λειτουργίας και τη βελτίωση της ποιότητας ζωής.

Γιατί να Επιλέξετε το Μικροβιολογικό Κέντρο της Homed
Η Homed προσφέρει γρήγορες και αξιόπιστες υπηρεσίες υγείας. Ορισμένα πλεονεκτήματα του κέντρου μας είναι:
- Γρήγορη Παράδοση Αποτελεσμάτων: Τα αποτελέσματα είναι διαθέσιμα την ίδια ημέρα και αποστέλλονται στο email σας για άμεση ενημέρωση.
- Προσωπική Φροντίδα: Οι υπηρεσίες μας προσαρμόζονται στις ανάγκες σας, με στόχο την πρόληψη και τη γρήγορη διάγνωση.
- Σύγχρονος Εξοπλισμός: Το εργαστήριο μας διαθέτει τελευταίας τεχνολογίας εξοπλισμό για ακριβείς και αξιόπιστες εξετάσεις.
- Εξειδικευμένο Προσωπικό: Η ομάδα μας αποτελείται από επαγγελματίες υγείας έτοιμους να σας προσφέρουν την καλύτερη φροντίδα.

Επικοινωνήστε μαζί μας
Για περισσότερες πληροφορίες ή για να προγραμματίσετε το ραντεβού σας, επικοινωνήστε μαζί μας. Είμαστε εδώ για να σας βοηθήσουμε.
Τηλέφωνο: Καλέστε μας στο +30 210 80 600 98 για πληροφορίες και ραντεβού.
Email: Επικοινωνήστε με το email μας στο info@homed.gr.
Κλείστε το ραντεβού σας πατώντας στην εικόνα παρακάτω.
Πρόληψη Διάγνωση Μικροβιολογικό Homed
